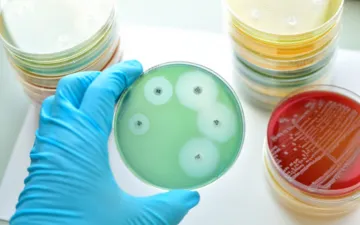

MIDDLE EAST TESTING SERVICES W.L.L QATAR
MIDDLE EAST TESTING SERVICES W.L.L QATAR

PHARMACEUTICAL & HEALTHCARE TESTING

PHARMACEUTICAL, HEALTHCARE & MEDICAL TESTING
Stay Informed With METS Laboratories
Connect with us and get to know about our latest updates and service details
Need specialized chemical testing? Share your project details with us, and we'll provide a
personalized quote to meet your requirements